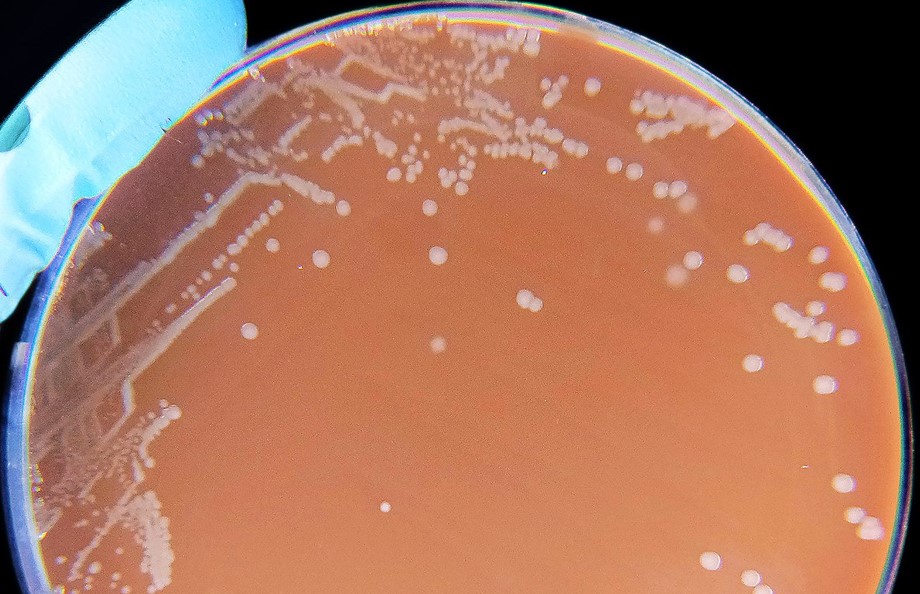

Categories for Uncategorised

Lancet’s Panel Investigating Covid Origins Disbanded Because of Ties to Peter Daszak
A panel of scientists affiliated to the Lancet which has been investigating the origins of Covid has been disbanded because of its ties to Peter Daszak, the President of EcoHealth Alliance.
Read more
Does COVID-19 Have a Hidden Helper That Sometimes Makes it Deadly?
The Spanish flu and Swine flu are both made much worse when a particular bacterium is present at the same time. Could Covid behave similarly?
Read more
News Round-Up
A summary of all the most interesting stories that have appeared about politicians’ efforts to control the virus — and other acts of hubris and folly – not just in Britain, but around the world.
Read more
Dutch Protest Against Vaccine Passports
People have gathered in The Hague, Netherlands, to protest against the "medical apartheid" barring those who haven't been vaccinated or tested for Covid from bars, restaurants and theatres.
Read more
Kenya and the U.K.’s Dog’s Breakfast of a Vaccine Passport Scheme
Spectator columnist Aidan Hartley has written a guest post for the Daily Sceptic about Kenya and the U.K.'s vaccine passport scheme that is such a dog's breakfast it is damaging relations between the two countries.
Read more
Decline in Flu Immunity Due to Clampdown on Socialising Has Led to ‘Worst Colds Ever’
Brits are complaining about their 'worst cold ever', with scientists saying that the decline in flu immunity during long, continued lockdowns could be a bigger problem this winter than Covid.
Read more
Unvaccinated Brits Could Be Barred from Royal Albert Hall Performances If Event Organisers Demand Vaccine Passports
The Chief Executive Officer at the Royal Albert Hall says the venue will "respect" the wishes of event organisers if they ask for unvaccinated concertgoers to be barred.
Read more
Covid Cases Fall After Schools Reopen In Spite of Widespread Predictions to the Contrary
Covid infections have plummeted despite fears that the new school term would fuel an autumn surge, according to the latest ONS data.
Read more
News Round-Up
A summary of all the most interesting stories that have appeared about politicians’ efforts to control the virus — and other acts of hubris and folly – not just in Britain, but around the world.
Read more
U.K. Set to Join E.U.’s Covid Vaccine Passport Scheme – Would Make Launching Domestic Passport Scheme Quicker
Britain is set to join the E.U.'s vaccine passport scheme. "To make journeys easier," according to Government officials. Joining it would also enable ministers to launch a domestic passport system more quickly.
Read more